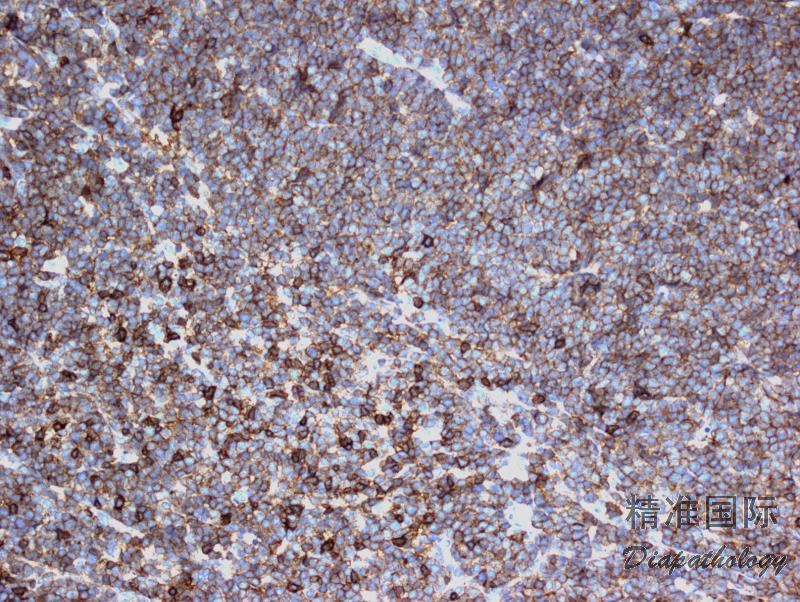

套细胞淋巴瘤
Mantle Cell Lymphoma, MCL
概述:
套细胞淋巴瘤(MCL)是一种侵袭性的 B 细胞肿瘤,由单形性、小到中等淋巴细胞组成,细胞核不规则。其遗传学特点是 CCND1 易位(>95%),导致 Cyclin D1 持续过度表达。
发病部位: 淋巴结、脾脏、骨髓,外周血也常类及。结外累及部位有胃肠道和 Waldeyer 环等。
诊断要点:
发病中位年龄为 60 岁,男性较多。大多数患者表现为晚期病变,如全身淋巴结及肝脾肿大并累及骨髓。外周血也常有瘤细胞,有的病例甚至类似于幼淋巴细胞白血病。
淋巴结正常结构消失,肿瘤常以三种方式生长:沿套区侵润,结节状侵润,弥漫性侵润。以上三种生长方式可以混合存在。瘤细胞小到中等,大小一致,核不规则,胞浆少,无核仁。无转化细胞(中心母细胞)和增殖中心。可有散在上皮样组织细胞。
免疫表型:表达 B 细胞抗原并共表达 CD5(CD43 也可阳性),cyclin-D1 阳性(>95%病例),SOX11 阳性(>90%病例,包括 cyclin-D1 阴性病例),MUM1 有时阳性。少见或罕见的表型有如 CD5-、Bcl6+、CD10+。CD20 和轻链中等强度阳性(流式这一特点有助于与 CLL 鉴别),CD23 弱阳性或阴性,CD200 通常阴性(非结性者可阳性)。
t (11;14) (>95%病例)。可同时存在其它遗传学改变,如 MYC、BCL6. TP53 等基因异常、复杂核型和一些基因的突变(如 NOTCH)。
形态学变异:
母细胞样套细胞瘤:细胞小到中等,核圆形、染色质稀疏似淋巴母,分裂指数高(最低 20-30%)。复杂染色体核型,临床侵袭性强,预后差。
多形性套细胞瘤:细胞大小不等包括很多大细胞,核仁突出,分裂指数高。复杂染色体核型,临床侵袭性强,预后差。
边缘区样套细胞瘤:细胞含较丰富胞浆,淡染,类似边缘区细胞。
小细胞型套细胞瘤:细胞与小细胞淋巴瘤类似,无幼淋巴细胞或副免疫母淋巴细胞,cyclin D1 阳性。
变异型:
1. Cyclin-D1 阴性套细胞瘤 :极少见。临床表现、形态学和基因表达图谱与典型 MCL 相同,但不表达 Cyclin-D1,没有 t(11;14)。然而,一般 SOX11 +。对于 SOX11 也阴性的病例,诊断需极其谨慎。免疫组化 cyclin-D2 或 cyclin-D3 有可能阳性,但对确诊没有帮助,因其它淋巴瘤也可阳性。另外,也有罕见病例免疫组化 cyclin-D1+,但检测不到 t(11;14)。
原位套细胞瘤变(in situ mantle cell neoplasia): 背景为反应性改变(滤胞增生),Cyclin-D1+/t(11;14)+瘤细胞通常仅累及套的内侧或内圈,偶也可累及套区外侧部分或散在累及整个套区、或累及滤胞内。外周血发现循环瘤细胞不影响对原位套细胞瘤变的诊断。免疫组化经常 CD5 阴性,部分病例 SOX11-,有些可能系白血病样非结性套细胞淋巴瘤累及淋巴结或结外组织。需注意与 MCL 套区生长模式相鉴别,如果整个套组弥漫累及伴套区扩大,应诊断为 MCL 为宜。原位套细胞瘤变患者临床过程惰性,可长期存活,但有的同时伴有其它淋巴瘤或进展成典型的 MCL。
白血病样非结性套细胞淋巴瘤(leukemic non-nodal mantle cell lymphoma): 患者表现为套细胞淋巴瘤累及外周血和骨髓,有时也累及脾脏,但不累及淋巴结(小于 1-2 cm)。肿瘤细胞形态常类似慢性淋巴细胞白血病,并可以植入淋巴结套区(形态与原位套细胞瘤变重叠),也可浸润结外炎性部位(如 H. pylori 感染性胃炎)。免疫组化 cyclin-D1+,但一般不表达 SOX11,CD5 阴性者也较多,且部分病例表达 CD200。遗传学有 t(11;14),但不像典型 MCL 常有复杂核型。预后较典型 MCL 好,临床相对惰性。但有的病例进展为侵袭性,伴或不伴淋巴结肿大,或转化为母细胞样或多形性。

免疫组织化学染色:
表达 B 细胞抗原并共表达 CD5(CD43 也可阳性),cyclin D1. SOX11 阳性。在流式,CD20 和轻链中等强度阳性,这一特点有助于与 CLL 鉴别。
分子标记:
CCND1 易位
鉴别诊断:
- 弥漫性大 B 细胞淋巴瘤 :形态类似多形性变异型,但不表达 cyclin D1。需注意的是,弥漫大 B 细胞瘤有表达 CD5 亚型也有表达 cyclin D1 亚型,但前者不表达 cyclin D1,后者无 t(11;14)。
- 淋巴母细胞淋巴瘤 :形态与母细胞样套细胞瘤相似,但表达不成熟抗原 CD34 和 TdT,而不表达 cyclin D1。
- 慢性淋巴细胞白血病/小淋巴细胞淋巴瘤 :组织学存在增殖中心,由小淋巴细胞,幼淋细胞和副免疫母细胞混合构成。CD20 和轻链弱表达,不表达 cyclin D1。慢性淋巴细胞白血病和免疫学与白血病样非结性 MCL 形态学可相似,免疫学也有相似之处(如两者多可以 CD5+、SOX11-),但后者 cyclin-D1+/t(11;14)+。
- 滤泡性淋巴瘤 :异常结节(生发中心)由中心细胞和中心母细胞组成,表达 CD10 和 Bcl-6,但不表达 cyclin D1。
- 淋巴结边缘区淋巴瘤 :弥漫或边缘区生长,常有单核细胞样改变,不表达 cyclin D1, CD5 一般也阴性。
预后:
存活期 3-5 年。分裂指数高(>30%)、母细胞变异、多形性变异、复杂染色体异常预后
治疗:
CHOP,hyper-CVAD,干细胞移植
